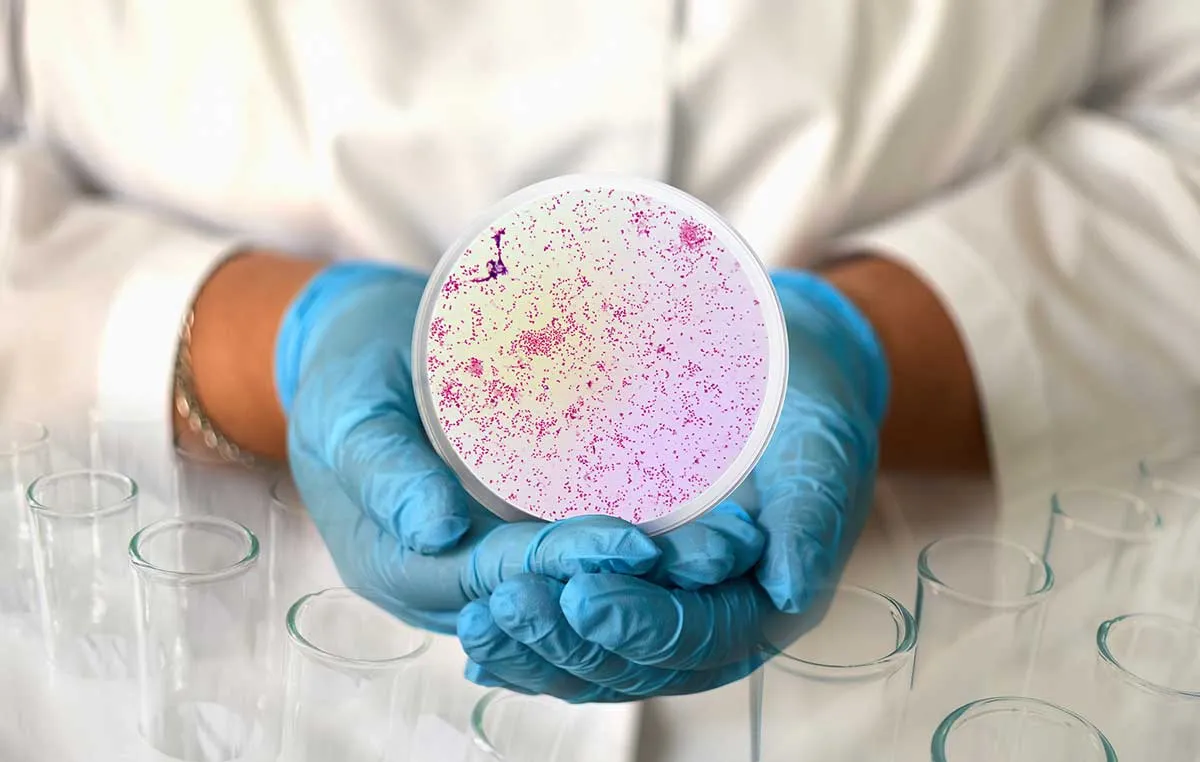

Superiority of RT-PCR Tests for the Detection of Respiratory Viruses at the Point-of-Care: A Summary of the Literature
A review of published studies finds RT-PCR tests consistently outperform rapid antigen and isothermal amplification methods in sensitivity—delivering lab-quality results at the point of care.

Point-of-Care STI Test by Visby Medical Enables Faster, More Targeted Treatment in the Johns Hopkins Medicine Emergency Department
Significant improvement to patient care and antimicrobial stewardship with appropriate use of antibiotics may be achieved through the use of rapid point-of-care PCR STI testing.
Antimicrobial stewardship, rapid PCR and STI
Significant improvement to patient care and antimicrobial stewardship with appropriate use of antibiotics may be achieved through the use of rapid point-of-care PCR STI testing.

Analytical Evaluation of Visby Medical RT-PCR Portable Device for Rapid Detection of SARS-CoV-2
While showing an analytical sensitivity slightly below that of a standard RT-qPCR system, the evaluated Visby RT-PCR POC device may prove to be an interesting diagnostic alternative in the COVID-19 pandemic, potentially combining the practical advantages of rapid antigen tests and the robust analytical performances of nucleic acid detection systems.

Lancet publishes paper on the Visby Medical point-of-care PCR technology
A study of the performance of the Visby Medical Sexual Health Test, a single-use, point-of-care PCR device.